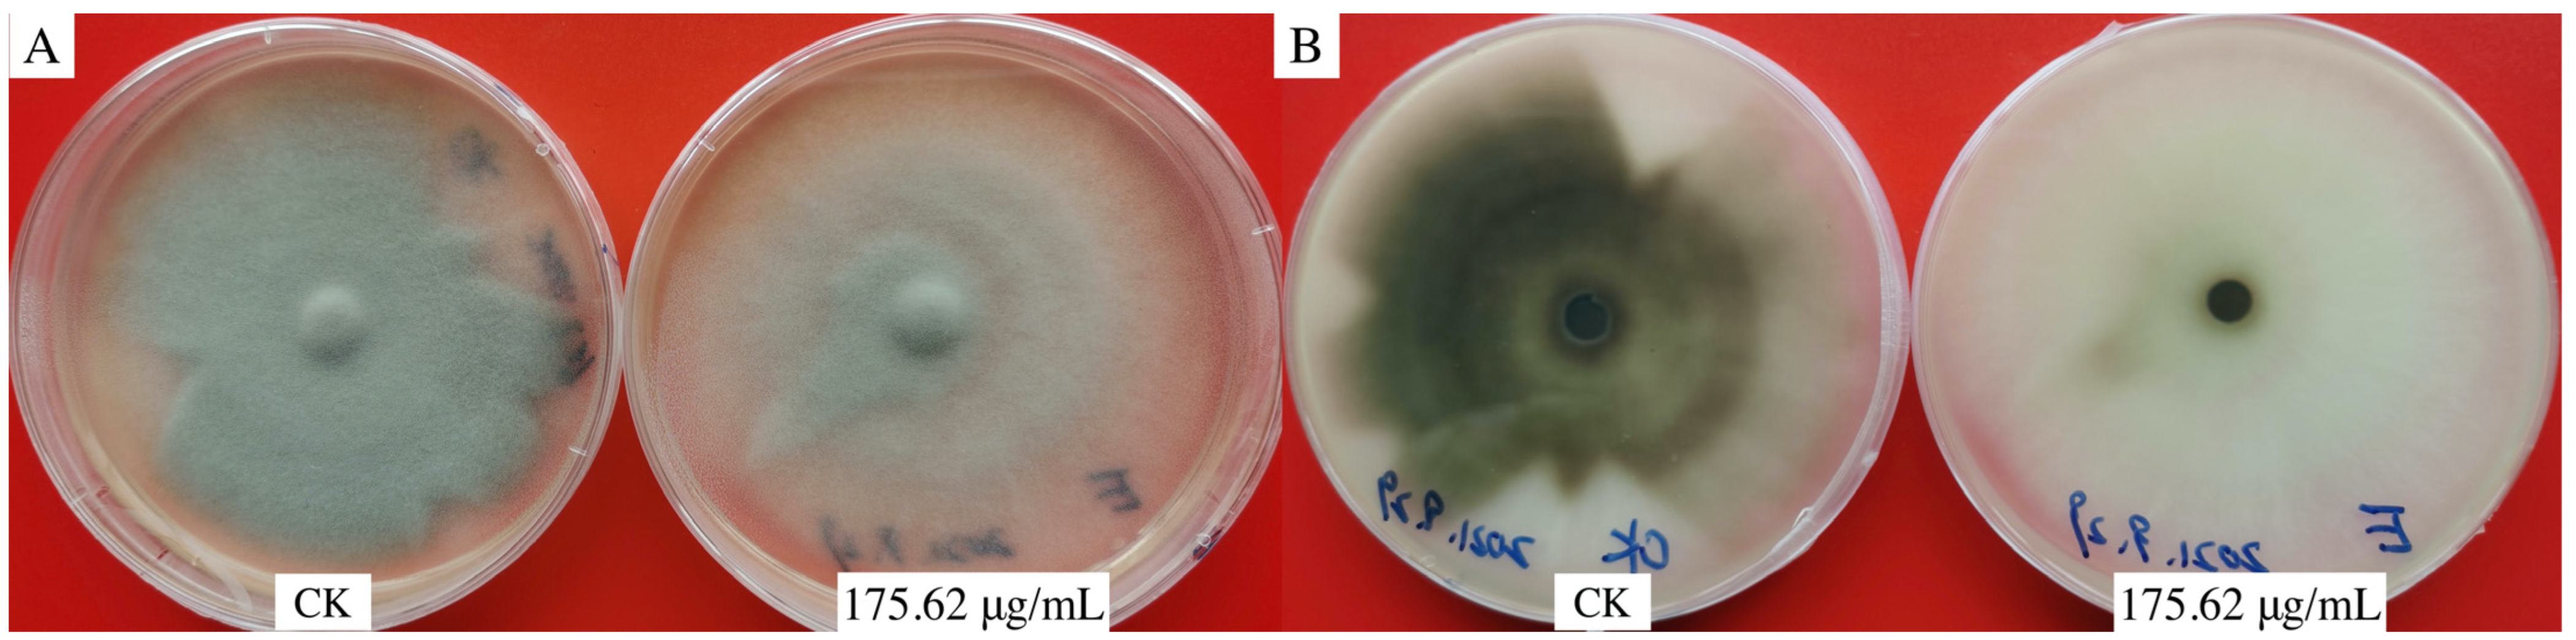

Natural Product Aloesin Significantly Inhibits Spore Germination and Appressorium Formation in Magnaporthe oryzae
Abstract
:1. Introduction
2. Materials and Methods
2.1. Magnaporthe oryzae
2.2. Effects of Aloesin on the Morphology of the Appressorium
2.3. Inhibitory Effect of Aloesin on Hyphae and Appressoria of M. oryzae
2.4. Enzyme Activity Analysis
2.5. Control Efficacy of Aloesin
2.6. Data Analysis
2.7. Labeling Free Proteomic Analysis
2.7.1. Protein Extraction
2.7.2. Protein Digestion and Desalination
2.7.3. Peptide Identification Using Nano UPLC-MS/MS
2.7.4. Proteomic Data Analysis
3. Results
3.1. Effects of Aloesin on the Morphology of Hyphae and Appressorium of M. oryzae
3.2. Inhibitory Effect of Aloesin on Hyphae and Appressorium of M. oryzae
3.3. Effect of Aloesin on Enzyme Activity of M. oryzae
3.4. Control Efficacy of Aloesin
3.5. Labeling Free Proteomic Analysis
4. Discussion
5. Conclusions
Author Contributions
Funding
Data Availability Statement
Acknowledgments
Conflicts of Interest
References
- Couch, B.C.; Fudal, I.; Lebrun, M.-H.; Tharreau, D.; Valent, B.; Van Kim, P.; Notteghem, J.-L.; Kohn, L.M. Origins of host-specific populations of the blast pathogen Magnaporthe oryzae in crop domestication with subsequent expansion of pandemic clones on rice and weeds of rice. Genetics 2005, 170, 613–630. [Google Scholar] [CrossRef] [PubMed]
- Uda, M.N.A.; Shaari, N.H.; Said, N.S.; Ibrahim, N.H.; Akhir, M.A.M.; Hashim, M.K.R.; Salimi, M.N.; Nuradibah, M.A.; Hashim, U.; Gopinath, S.C.B. Antimicrobial activity of plant extracts from Aloe vera, Citrus hystrix, Sabah snake grass and Zingiber officinale against Pyricularia oryzae that causes rice blast disease in paddy plants. IOP Conf. Ser. Mater. Sci. Eng. 2018, 318, 012009. [Google Scholar] [CrossRef]
- Bussaban, B.; Lumyong, S.; Lumyong, P.; Seelanan, T.; Park, D.C.; McKenzie, E.H.C.; Hyde, K.D. Molecular and morphological characterization of Pyricularia and allied genera. Mycologia 2005, 97, 1002–1011. [Google Scholar] [CrossRef] [PubMed]
- Hubert, J.; Mabagala, R.B.; Mamiro, D.P. Efficacy of selected plant extracts against Pyricularia grisea, causal agent of rice blast disease. Am. J. Plant Sci. 2015, 6, 602–611. [Google Scholar] [CrossRef]
- Mohiddin, F.A.; Bhat, N.A.; Wani, S.H.; Bhat, A.H.; Ahanger, M.A.; Shikari, A.B.; Sofi, N.R.; Parveen, S.; Khan, G.H.; Bashir, Z.; et al. Combination of Strobilurin and Triazole Chemicals for the Management of Blast Disease in Mushk Budji -Aromatic Rice. J. Fungi 2021, 7, 1060. [Google Scholar] [CrossRef] [PubMed]
- Sánchez-Sanuy, F.; Mateluna-Cuadra, R.; Tomita, K.; Okada, K.; Sacchi, G.A.; Campo, S.; San Segundo, B. Iron induces resistance against the rice blast fungus Magnaporthe oryzae through potentiation of immune responses. Rice 2022, 15, 68. [Google Scholar] [CrossRef]
- Zhou, A.A.; Li, R.Y.; Mo, F.X.; Ding, Y.; Li, R.T.; Guo, X.; Hu, K.; Li, M. Natural product citronellal can significantly disturb chitin synthesis and cell wall integrity in Magnaporthe oryzae. J. Fungi 2022, 8, 1310. [Google Scholar] [CrossRef]
- Huang, P.; Li, Y.; Wang, J.; Wang, Q.; Huang, Z.; Liu, X.; Lin, F.; Lu, J. Casein Kinase 2 Mediates Degradation of Transcription Factor Pcf1 during Appressorium Formation in the Rice Blast Fungus. J. Fungi 2022, 8, 144. [Google Scholar] [CrossRef]
- Liu, C.; Shen, N.; Zhang, Q.; Qin, M.; Cao, T.; Zhu, S.; Tang, D.; Han, L. Magnaporthe oryzae Transcription Factor MoBZIP3 Regulates Appressorium Turgor Pressure Formation during Pathogenesis. Int. J. Mol. Sci. 2022, 23, 881. [Google Scholar] [CrossRef]
- Cooper, J.; Donofrio, N. Regulators unite to enable plant entry. Nat. Microbiol. 2021, 6, 1349–1350. [Google Scholar] [CrossRef]
- Li, R.Y.; Wu, X.M.; Yin, X.H.; Long, Y.H.; Li, M. Naturally produced citral can signifificantly inhibit normal physiology and induce cytotoxicity on Magnaporthe grisea. Pestic Biochem. Phys. 2015, 118, 19–25. [Google Scholar] [CrossRef]
- Song, X.; Zhao, Q.; Zhou, A.; Wen, X.; Li, M.; Li, R.; Liao, X.; Xu, T. The Antifungal Effects of Citral on Magnaporthe oryzae Occur via Modulation of Chitin Content as Revealed by RNA-Seq Analysis. J. Fungi 2021, 7, 1023. [Google Scholar] [CrossRef] [PubMed]
- Amadioha, A.C. Controlling rice blast in vitro and in vivo with extracts of Azadirachta indica. Crop Prot. 2000, 19, 287–290. [Google Scholar] [CrossRef]
- Zhao, Q.; Ding, Y.; Song, X.; Liu, S.; Li, M.; Li, R.; Ruan, H. Proteomic analysis reveals that naturally produced citral can significantly disturb physiological and metabolic processes in the rice blast fungus Magnaporthe oryzae. Pesti. Biochem. Phys. 2021, 175, 104835. [Google Scholar] [CrossRef]
- Bowers, J.H.; Locke, J.C. Effect of botanical extracts on the population density of Fusarium oxysporum in soil and control of Fusarium wilt in the greenhouse. Plant Dis. 2000, 84, 300–305. [Google Scholar] [CrossRef] [PubMed]
- Wang, W.; Ben-Daniel, B.H.; Cohen, Y. Control of plant diseases by extracts of Inula viscosa. Phytopathology 2004, 94, 1042–1047. [Google Scholar] [CrossRef] [PubMed]
- Lalitha, V.; Raveesha, K.A.; Kiran, B. Antimicrobial activity of Solanum torvum Swart against important seed borne pathogens of paddy. Iran. J. Energy Environ. 2010, 1, 160–164. [Google Scholar]
- Gurjar, M.S.; Ali, S.; Akhtar, M.; Singh, K.S. Efficacy of plant extracts in plant disease management. Agric. Sci. 2012, 3, 425–433. [Google Scholar] [CrossRef]
- Jyotsna, J.; Das, S.; Kumar, B. Efficacy of aqueous leaf extract of medicinal plants against blast and brown spot disease of rice. Int. J. Curr. Microbiol. Appl. Sci. 2017, 6, 4138–4144. [Google Scholar] [CrossRef]
- Campestrini, L.H.; Silveira, J.L.M.; Duarte, M.E.R.; Koop, H.S.; Noseda, M.D. NMR and rheological study of Aloe barbadensis partially acetylated glucomannan. Carbohydr. Polym. 2013, 94, 511–519. [Google Scholar] [CrossRef]
- Park, Y.I.; Jo, T.H. Perspective of industrial application of Aloe vera. In New Perspectives on Aloe; Springer: Boston, MA, USA, 2006; pp. 191–200. [Google Scholar]
- Lin, C.W.; Wu, C.F.; Hsiao, N.W.; Chang, C.Y.; Li, S.W.; Wan, L.; Lin, Y.J.; Lin, W.Y. Aloe-emodin is an interferon-inducing agent with antiviral activity against Japanese encephalitis virus and enterovirus 71. Int. J. Antimicrob. Agents 2008, 32, 355–359. [Google Scholar] [CrossRef]
- López, B.P.; Calvarro, L.M.; Piñón, D.; Esteban, A.; Tello, M.L.; Carril EP, U.; Garay, A.G. Antifungal effects of phenolic extract from industrial residues of Aloe Vera. Span. J. Agric. Res. 2019, 16, 1010. [Google Scholar]
- Añibarro-Ortega, M.; Pinela, J.; Ćirić, A.; Lopes, E.; Molina, A.K.; Calhelha, R.C.; Soković, M.; Ferreira, O.; Ferreira, I.C.F.R.; Barros, L. Extraction of Aloesin from Aloe vera Rind Using Alternative Green Solvents: Process Optimization and Biological Activity Assessment. Biology 2021, 10, 951. [Google Scholar] [CrossRef]
- Lynch, B.; Simon, R.; Roberts, A. Subchronic toxicity evaluation of aloesin. Regul. Toxicol. Pharmacol. 2011, 61, 161–171. [Google Scholar] [CrossRef]
- Ogbebor, N.; Adekunle, A.T. Inhibition of conidial germination and mycelial growth of Corynespora cassiicola (Berk and Curt) of rubber (Hevea brasiliensis Muell. Arg.) using extracts of some plants. Aft. J. Biotechnol. 2005, 4, 996–1000. [Google Scholar]
- Reyna Nathan, S.; Yang, Y. Molecular analysis of the rice MAP kinase gene family in relation to Magnaporthe grisea infection. Mol. Plant-Microbe Interact. MPMI 2006, 19, 530–540. [Google Scholar] [CrossRef] [PubMed]
- You, X.; Guo, B.; Wang, Z.; Ma, H.; Zhang, X. Label-free quantitative proteomic analysis of serum exosomes from patients of renal anemia: The Good and the Bad of Roxadustat. Clin. Proteom. 2022, 19, 21. [Google Scholar] [CrossRef] [PubMed]
- Sun, Z.; Li, L.; Qu, J.; Li, H.; Chen, H. Proteomic analysis of therapeutic effects of Qingyi pellet on rodent severe acute pancreatitis-associated lung injury. Biomed. Pharmacother. 2019, 118, 109300. [Google Scholar] [CrossRef] [PubMed]
- Dean, R.; Van Kan, J.A.; Pretorius, Z.A.; Hammond-Kosack, K.E.; Di Pietro, A.; Spanu, P.D.; Rudd, J.J.; Dickman, M.; Kahmann, R.; Ellis, J.; et al. The Top 10 fungal pathogens in molecular plant pathology. Mol. Plant Pathol. 2012, 13, 414–430. [Google Scholar] [CrossRef]
- Li, Y.-B.; Xu, R.; Liu, C.; Shen, N.; Han, L.-B.; Tang, D. Magnaporthe oryzae fimbrin organizes actin networks in the hyphal tip during polar growth and pathogenesis. PLoS Pathog. 2020, 16, e1008437. [Google Scholar] [CrossRef]
- Cai, X.; Zhang, X.; Li, X.; Liu, M.; Liu, X.; Wang, X.; Zhang, H.; Zheng, X.; Zhang, Z. The atypical guanylate kinase MoGuk2 plays important roles in asexual/sexual development, conidial septation, and pathogenicity in the rice blast fungus. Front. Microbiol. 2017, 8, 2467. [Google Scholar] [CrossRef]
- Howard, R.J.; Ferrari, M.A.; Roach, D.H.; Money, N.P. Penetration of hard substrates by a fungus employing enormous turgor pressures. Proc. Natl. Acad. Sci. USA 1991, 88, 11281–11284. [Google Scholar] [CrossRef]
- Saunders, D.G.O.; Aves, S.J.; Talbot, N.J. Cell cycle-mediated regulation of plant infection by the rice blast fungus. Plant Cell 2010, 22, 497–507. [Google Scholar] [CrossRef]
- Langfelder, K.; Streibel, M.; Jahn, B.; Haase, G.; Brakhage, A.A. Biosynthesis of fungal melanins and their importance for human pathogenic fungi. Fungal Genet. Biol. 2003, 38, 143–158. [Google Scholar] [CrossRef] [PubMed]
- Li, L.W.; Chen, X.L.; Zhang, S.P.; Yang, J.; Chen, D.; Liu, M.X.; Zhang, H.; Zheng, X.; Wang, P.; Peng, Y.; et al. MoCAP proteins regulated by MoArk1-mediated phosphorylation coordinate endocytosis and actin dynamics to govern development and virulence of Magnaporthe oryzae. PLoS Genet. 2017, 13, e1006814. [Google Scholar] [CrossRef] [PubMed]
- Li, X.; Gao, C.; Li, L.; Liu, M.; Yin, Z.; Zhang, H.; Zheng, X.; Wang, P.; Zhang, Z. MoEnd3 regulates appressorium formation and virulence through mediating endocytosis in rice blast fungus Magnaporthe oryzae. PLoS Pathog. 2017, 13, 1006449. [Google Scholar] [CrossRef]
- Ryder, L.S.; Dagdas, Y.F.; Mentlak, T.A.; Kershaw, M.J.; Thornton, C.R.; Schuster, M.; Chen, J.; Wang, Z.; Talbot, N. NADPH oxidases regulate septin-mediated cytoskeletal remodeling during plant infection by the rice blast fungus. Proc. Natl. Acad. Sci. USA 2013, 110, 3179–3184. [Google Scholar] [CrossRef]
- Wang, C.L.; Shaw, B.D. F-actin localization dynamics during appressorium formation in Colletotrichum graminicola. Mycologia 2016, 108, 506–514. [Google Scholar] [CrossRef]
- Garduño-Rosales, M.; Callejas-Negrete, O.A.; Medina-Castellanos, E.; Bartnicki-García, S.; Herrera-Estrella, A.; Mouriño-Pérez, R.R. F-actin dynamics following mechanical injury of Trichoderma atroviride and Neurospora crassa hyphae. Fungal Genet. Biol. 2022, 159, 103672. [Google Scholar] [CrossRef]
- Mooren, O.L.; Galletta, B.J.; Cooper, J.A. Roles for actin assembly in endocytosis. Annu. Rev. Biochem. 2012, 81, 661–686. [Google Scholar] [CrossRef]
- Li, J.; Blanchoin, L.; Staiger, C.J. Signaling to actin stochastic dynamics. Annu. Rev. Plant. Biol. 2015, 66, 415–440. [Google Scholar] [CrossRef]
- Echauri-Espinosa, R.O.; Callejas-Negrete, O.A.; Roberson, R.W.; Bartnicki-Garcia, S.; Mourino-Perez, R.R. Coronin Is a Component of the Endocytic Collar of Hyphae of Neurospora crassa and Is Necessary for Normal Growth and Morphogenesis. PLoS ONE 2012, 7, 38237. [Google Scholar] [CrossRef]
- Bartnicki-Garcia, S.; Garduno-Rosales, M.; Delgado-Alvarez, D.L.; Mourino-Perez, R.R. Experimental measurement of endocytosis in fungal hyphae. Fungal Genet. Biol. 2018, 118, 32–36. [Google Scholar] [CrossRef] [PubMed]
- Berepiki, A.; Lichius, A.; Shoji, J.Y.; Tilsner, J.; Read, N.D. F-actin dynamics in Neurospora crassa. Eukaryot. Cell 2010, 9, 547–557. [Google Scholar] [CrossRef] [PubMed]
- Delgado-Alvarez, D.L.; Callejas-Negrete, O.A.; Gomez, N.; Freitag, M.; Roberson, R.W.; Smith, L.G.; Mouriño-Pérez, R. Visualization of F-actin localization and dynamics with live cell markers in Neurospora crassa. Fungal Genet. Biol. 2010, 47, 573–586. [Google Scholar] [CrossRef] [PubMed]
- Xu, J.R.; Staiger, C.J.; Hamer, J.E. Inactivation of the mitogen-activated protein kinase Mps1 from the rice blast fungus prevents penetration of host cells but allows activation of plant defense responses. Proc. Natl. Acad. Sci. USA 1998, 95, 12713–12718. [Google Scholar] [CrossRef] [PubMed]

Disclaimer/Publisher’s Note: The statements, opinions and data contained in all publications are solely those of the individual author(s) and contributor(s) and not of MDPI and/or the editor(s). MDPI and/or the editor(s) disclaim responsibility for any injury to people or property resulting from any ideas, methods, instructions or products referred to in the content. |
© 2023 by the authors. Licensee MDPI, Basel, Switzerland. This article is an open access article distributed under the terms and conditions of the Creative Commons Attribution (CC BY) license (https://creativecommons.org/licenses/by/4.0/).
Share and Cite
Zhang, G.; Li, R.; Wu, X.; Li, M. Natural Product Aloesin Significantly Inhibits Spore Germination and Appressorium Formation in Magnaporthe oryzae. Microorganisms 2023, 11, 2395. https://doi.org/10.3390/microorganisms11102395
Zhang G, Li R, Wu X, Li M. Natural Product Aloesin Significantly Inhibits Spore Germination and Appressorium Formation in Magnaporthe oryzae. Microorganisms. 2023; 11(10):2395. https://doi.org/10.3390/microorganisms11102395
Chicago/Turabian StyleZhang, Guohui, Rongyu Li, Xiaomao Wu, and Ming Li. 2023. "Natural Product Aloesin Significantly Inhibits Spore Germination and Appressorium Formation in Magnaporthe oryzae" Microorganisms 11, no. 10: 2395. https://doi.org/10.3390/microorganisms11102395
APA StyleZhang, G., Li, R., Wu, X., & Li, M. (2023). Natural Product Aloesin Significantly Inhibits Spore Germination and Appressorium Formation in Magnaporthe oryzae. Microorganisms, 11(10), 2395. https://doi.org/10.3390/microorganisms11102395





